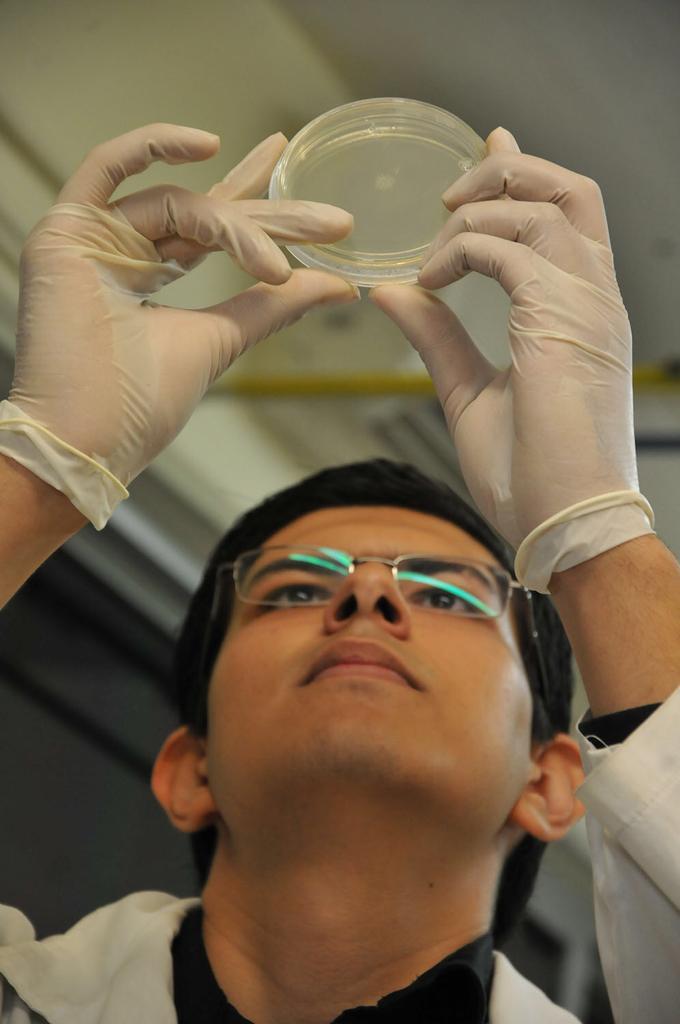

Gracias a la visión global y al dinamismo en las políticas que impulsa la administración central, que encabeza el Rector, doctor Juan Eulogio Guerra Liera, la Universidad Autónoma de Sinaloa (UAS), continúa avanzando con paso firme en el fortalecimiento, consolidación e internacionalización de sus programas educativos.
Muestra de ello son los posgrados que oferta la institución y que en su mayoría están inscritos en el Padrón Nacional de Posgrados de Calidad de CONACyT, como lo es el Doctorado en Ciencia y Tecnología de Alimentos que ofrece la Facultad de Ciencias Químico Biológicas, el cual desde su creación ha sido reconocido por sus altos estándares de calidad, manifestó el director de esta unidad académica, doctor Jorge Milán Carrillo.
“Es un promedio de 30 años que este posgrado en Ciencia y Tecnología de Alimentos ha sido reconocido a nivel nacional por su calidad. Con el transcurso del crecimiento y desarrollo de la investigación en la universidad empezamos a ampliar los posgrados en la facultad y por supuesto, en la institución”, declaró.

Resaltó que, desde entonces se ha trabajado fuertemente en la elevación de los indicadores de calidad educativa y en la pertinencia de los posgrados, mencionando que, a inicios del 2020, el doctorado fue evaluado nuevamente para renovar su vigencia en el Padrón Nacional de Posgrados de Calidad (PNPC) del Consejo Nacional de Ciencia y Tecnología (CONACyT), logrando el nivel de consolidación.
“Hoy podemos decir que el Doctorado en Ciencia y Tecnología de Alimentos está reconocido como un programa de calidad en etapa de consolidación, lo que significa que este programa cuenta con investigación de calidad pertinente, que está formando recursos humanos de calidad debido a que cuenta con un núcleo básico de profesores que tienen una alta formación académica”, enfatizó.
Parte de esta distinción, indicó el docente universitario, se debe a la calidad formativa del estudiante ya que la mayoría de los egresados de este programa pertenecen al Sistema Nacional de Investigadores (SNI).
“Quiere decir que un miembro del Sistema Nacional de Investigadores es un profesor que está considerado como un investigador con carácter nacional, que forma recursos humanos de calidad, que investiga áreas pertinentes en el país”, explicó.
En ese sentido, destacó la importancia del apoyo del Rector de la centenaria Casa de Estudios para consolidar la calidad académica de este programa, pues señaló que, gracias al impulso que se les ha dado a proyectos como el de Doctores Jóvenes y al soporte económico que brinda al área de la investigación, aún y pese al recorte financiero que ha sufrido la institución, hoy la Facultad cuenta con posgrados reconocidos por su pertinencia y calidad a nivel nacional.
“El hecho de la continuidad de los programas de Doctores Jóvenes, formación de recursos humanos de calidad, lo que se llama la nueva generación, es una aportación importante del Rector titular de esta universidad, el doctor Guerra Liera. El otro punto importante es que para poder desarrollar investigación se ocupa financiamiento, entonces, somos de las pocas universidades que seguimos teniendo financiamiento interno, lo que se conoce como Programa de Fomento a la Investigación”, subrayó.

Asimismo, destacó que prueba de la calidad académica e investigativa del doctorado, es la obtención en diversos años del Premio Nacional en Ciencia y Tecnología de Alimentos por las aportaciones científicas de profesores y estudiantes de este programa.
“En los últimos cinco años, miembros formados en la comunidad universitaria han logrado consolidar proyectos de investigación de calidad, en ese sentido, el apoyo fundamental que hemos tenido del Rector ha sido muy importante”, recalcó.
De igual forma, aseguró que el que la UAS pertenezca a organismos como la Asociación Universitaria Iberoamericana del Postgrado, impacta positivamente en la institución, ya que tanto estudiantes como profesores de programas de posgrados en maestría y doctorado podrán ampliar los lugares en los que pueden realizar intercambio académico con universidades internacionales.

De esta manera, dijo, se presenta una gran oportunidad para que los programas de maestría y doctorado alcancen la etapa “Con carácter internacional” del PNPC de CONACyT destacando en este punto, que el Doctorado en Ciencia y Tecnología de Alimentos cumple con los elementos para obtener en la próxima evaluación este nivel.